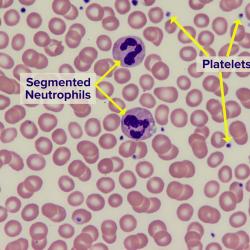
Thumbnail

To evaluate any change in the number of red blood cells in your blood
-
Tests
- 5-Hydroxyindoleacetic acid (5-HIAA)
- 17-Hydroxyprogesterone
- ACE
- Acetylcholine Receptor (AChR) Antibody
- Acid-Fast Bacillus (AFB) Testing
- ACT
- ACTH Test
- Acute Viral Hepatitis Testing
- Adenosine Deaminase
- ADH and Copeptin
- AFP Tumour Marker Test
- Alanine aminotransferase (ALT) Test
- Albumin
- Aldosterone and Renin
- ALK Mutation (Gene Rearrangement)
- Alkaline Phosphatase (ALP) Test
- Allergy Testing
- Alpha-1 Antitrypsin
- Ammonia
- Amniotic Fluid Analysis
- Amylase Test
- ANCA/MPO/PR3 Antibodies
- Anti-dsDNA
- Anti-LKM-1
- Anti-Mullerian Hormone
- Anticentromere Antibody
- Antimitochondrial Antibody and AMA M2
- Antinuclear Antibody (ANA) Test
- Antiphospholipid Antibodies
- Antithrombin
- Apo A
- Apo B
- Apolipoprotein E (Apo E) Genotyping
- aPTT
- Arbovirus Testing
- Aspartate aminotransferase (AST) Test
- Autoantibodies
- B Vitamins
- B-cell Immunoglobulin Gene Rearrangement
- B-Type Natriuretic Peptide (BNP) Test
- Bacterial Wound Culture
- BCR-ABL
- Beta-2 Glycoprotein 1 Antibodies
- Beta-2 Microglobulin Kidney Disease
- Beta-2 Microglobulin Tumour Marker
- Bicarbonate
- Bilirubin
- Blood Culture
- Blood Film
- Blood Gas Tests
- Blood Ketones
- Blood Typing
- Bone Markers
- Bone Marrow Aspiration and Biopsy
- BRCA-1 and BRCA-2 (Breast Cancer Gene 1 and 2) Tests
- C-peptide
- C-Reactive Protein (CRP)
- CA 15-3 Test
- Caeruloplasmin
- Calcitonin
- Calcium Test
- Calprotectin
- CALR Mutation
- Cancer Antigen 125 (CA125) Test
- Cancer Antigen 19-9 (CA 19-9) Test
- Carbamazepine
- Carcinoembryonic Antigen (CEA)
- Cardiac Biomarkers
- Cardiac Risk Assessment
- Cardiolipin Antibodies
- Catecholamines, plasma and urine
- CCP
- CD4 and CD8
- Cervical Cytology
- CF Gene Mutation Testing
- Chickenpox and Shingles Tests
- Chlamydia Test
- Chloride Test
- Cholesterol Test
- Cholinesterase Test
- Chromogranin A
- Ciclosporin
- CK-MB Test
- Clopidogrel (CYP2C19 Genotyping)
- Clostridioides difficile and C. difficile Toxin Testing
- Coagulation Cascade
- Coagulation Factors
- Coeliac Disease Tests
- Complement
- Continuous Glucose Monitoring
- Copper
- Coronavirus (COVID-19) Testing
- Cortisol Test
- Creatine Kinase (CK) Test
- Creatinine
- Creatinine Clearance
- Cryoglobulin
- CSF Analysis
- Cystatin C
- Cytomegalovirus (CMV)
- D-dimer
- DHEAS
- Digoxin
- Direct Antiglobulin Test
- Direct LDL Cholesterol
- Drugs of Abuse
- eGFR - estimated Creatinine Clearance
- Electrolytes and Anion Gap
- Emergency and Overdose Drug Testing
- ENA Panel
- Epstein-Barr Virus Antibodies
- Erythrocyte Sedimentation Rate (ESR)
- Erythropoietin (EPO)
- Ethanol (Alcohol)
- Factor V Leiden Mutation and PT 20210 Mutation
- Faecal Immunochemical Test
- Ferritin Test
- Fibrinogen
- First Trimester (Combined) Screen for Down’s Syndrome and other fetal anomalies
- Fructosamine
- FSH Test
- FT3
- FT4
- Full Blood Count (FBC)
- Fungal Tests
- G6PD
- Gamma-Glutamyl transferase (GGT) Test
- Gastrin
- Genetic Tests for Targeted Cancer Therapy
- Glucose Tests
- Gonorrhoea Test
- Gram Stain
- Growth Hormone
- Haemoglobin
- Haemoglobinopathy Evaluation
- Haptoglobin
- HbA1c Test
- HDL Cholesterol Test
- Heavy Metals
- Helicobacter Pylori Test
- Heparin Anti-Xa
- Heparin-induced Thrombocytopenia Antibody
- Hepatitis A Virus Antibodies
- Hepatitis B Virus Antibodies
- Hepatitis C Virus Antibodies
- HER-2 testing
- Herpes Testing
- Histamine
- HIV 1 Viral Load
- HIV Antibody and HIV Antigen (p24)
- HIV Resistance Testing
- HLA Testing
- HLA-B27
- Home Tests
- Homocysteine
- Hormone Receptor Status
- HPV Test
- hs-CRP
- HTLV
- Human chorionic gonadotrophin (hCG) Test
- IGF-1
- Immunophenotyping
- Immunoreactive Trypsin
- Influenza (Flu) Tests
- Insulin
- Interferon Gamma Release Assay
- Iron
- Iron Tests
- Islet Autoantibodies in Diabetes
- JAK2 Mutation
- Kidney Stone Analysis
- Kidney Stone Risk Panel
- Lactate
- Lactate dehydrogenase (LDH)
- Lactose Tolerance Tests
- LDL Cholesterol Test
- Lead Test
- Levetiracetam
- LH Test
- Lipase Test
- Lipid Profile
- Lithium
- Liver Blood Tests
- Lp(a)
- Lupus Anticoagulant
- Lyme Disease Tests
- Magnesium
- Measles and Mumps Tests
- Mercury
- Methotrexate
- Methylmalonic Acid
- Monospot Test
- MRSA Screening
- MTHFR
- Mycophenolic Acid
- Mycoplasma
- Myoglobin Test
- Nicotine/Cotinine
- Non-HDL Cholesterol Test
- Non-Invasive Prenatal Testing (NIPT)
- OCP
- Oestrogen
- Osmolality (Osmolarity)
- Paracetamol
- Parvovirus B19
- PCV
- Pericardial Fluid Analysis
- Peritoneal Fluid Analysis
- Pertussis
- Pharmacogenetic Tests
- Phenobarbital
- Phenytoin
- Phosphate
- Plasma Free Metadrenalines (Metanephrines)
- Plasma viscosity
- Platelet Count
- Platelet Function Tests
- Pleural Fluid Analysis
- Porphyrins
- Potassium Test
- Prealbumin Test
- Preoperative Tests
- Procalcitonin
- Progesterone Test
- Prolactin
- Prostate-Specific Antigen (PSA)
- Protein C and Protein S
- Protein Electrophoresis and Immunofixation Electrophoresis
- Prothrombin Time and International Normalised Ratio (PT/INR)
- PSEN1 Test
- PTH
- Quantitative Immunoglobulins
- RAS (KRAS and NRAS, all RAS) testing
- Red Blood Cell (RBC) Antibody Identification
- Red Blood Cell (RBC) Antibody Screen
- Red Blood Cell Count
- Red Cell Indices
- Renal Panel
- Reticulocyte Count
- Rheumatoid Factor
- RSV (Respiratory Syncytial Virus)
- Rubella Test
- Salicylate
- Second trimester maternal screening
- Selenium
- Semen Analysis
- Serotonin
- Sex Hormone Binding Globulin (SHBG)
- Shiga toxin-producing Escherichia coli
- Sickle Cell Test
- Sirolimus
- Smooth Muscle Antibody
- Sodium Test
- Soluble Mesothelin-Related Peptides
- Soluble Transferrin Receptor
- Sputum Culture
- Stool Culture
- Susceptibility Testing
- Sweat Chloride Test
- Synacthen Test
- Synovial Fluid Analysis
- Syphilis Test
- T-Cell Receptor Gene Rearrangement
- Tacrolimus
- Tau Protein
- TB Skin Test
- Testosterone Test
- Theophylline and Caffeine
- Therapeutic Drug Monitoring
- Throat Infection Test
- Thyroglobulin Test
- Thyroid Antibodies
- Thyroid Function Tests
- Thyroid-Stimulating Hormone (TSH)
- TIBC, UIBC and Transferrin
- TORCH Test
- Total Protein Test
- TPMT
- Trace Elements
- Trichomonas Test
- Triglycerides
- Troponin Test
- Tryptase
- Tumour Markers
- U&E
- Unvalidated or misleading laboratory tests
- Urea Test
- Uric Acid Test
- Urinalysis
- Urine Albumin to Creatinine Ratio or ACR
- Urine Culture
- Urine Metadrenalines (Metanephrines)
- Urine Protein and Urine Protein to Creatinine Ratio
- Valproic acid
- Vancomycin
- Vanillylmandelic Acid (VMA)
- Very Low Density Lipoprotein (VLDL)
- Vitamin A
- Vitamin B12 and Folate
- Vitamin D
- Vitamin K
- von Willebrand Factor
- Warfarin Sensitivity Testing
- West Nile Virus
- White Blood Cell Count
- White Blood Cell Differential Count
- Zinc
- Zinc Protoporphyrin
Tests Index Not Listed? Not Listed? -
Conditions/Diseases
- Acidosis and Alkalosis
- Acromegaly
- Adrenal Insuficiency and Addison Disease
- Alcoholism
- Allergies
- Alzheimer's Disease
- Amenorrhoea
- Anaemia
- Angina Pectoris
- Ankylosing Spondylitis
- Antiphospholipid Syndrome
- Arthritis
- Asthma
- Autoimmune Disorders
- Benign Prostatic Hypertrophy
- Bleeding Disorders
- Bone Marrow Disorders
- Bowel Cancer
- Breast Cancer
- Cardiovascular Disease (CVD)
- Cervical Cancer
- Chronic Fatigue Syndrome
- Cirrhosis
- Coeliac Disease
- Congenital Adrenal Hyperplasia
- Congestive Heart Failure
- Conn's Syndrome
- Cushing's syndrome
- Cystic Fibrosis
- Diabetes
- Diarrhoea
- Disseminated Intravascular Coagulation
- Down's Syndrome
- Epilepsy
- Fungal Infections
- Gallstones
- Gout
- Graves Disease
- Guillain-Barre
- Haematuria
- Haemochromatosis
- Hashimoto Thyroiditis
- Heart Attack and Acute Coronary Syndrome
- Heart Disease
- Hepatitis
- Human Immunodeficiency Virus (HIV)
- Huntington's disease
- Hypercoagulable Disorders
- Hypertension (High Blood Pressure)
- Hyperthyroidism
- Hypothyroidism
- Infertility
- Inflammatory Bowel Diseases
- Influenza
- Insulin Resistance
- Jaundice
- Juvenile Idiopathic Arthritis
- Kidney Disease
- Lactose Intolerance
- Lead Poisoning
- Leukaemia
- Liver Disease
- Lung Cancer
- Lung Diseases
- Lyme Disease
- Lymphoma
- Malabsorption
- Malnutrition
- Meningitis and Encephalitis
- Menopause
- Metabolic Syndrome
- Multiple Myeloma
- Multiple Sclerosis
- Myasthenia Gravis
- Myeloproliferative Neoplasms
- Neural Tube Defects
- Neuropathy
- Non-tuberculous (Atypical) Mycobacterium
- Osteoarthritis
- Osteoporosis
- Ovarian Cancer
- Pancreatic Cancer
- Pancreatic Diseases
- Pancreatic Exocrine Insufficiency
- Pancreatitis
- Pelvic Inflammatory Disease
- Peptic Ulcer
- Pituitary Disorders
- Pneumonia
- Polycystic Ovary Syndrome
- Porphyria
- Pre-eclampsia
- Pregnancy
- Prostate Cancer
- Proteinuria
- Reactive Arthritis
- Rheumatoid Arthritis
- Sarcoidosis
- Sepsis
- Septic Arthritis
- Sexually Transmitted Diseases
- Sickle Cell Anaemia
- Sjögren's Syndrome
- Staph Wound Infections and Methicillin Resistant Staphylococcus aureus
- Stroke
- Suxamethonium apnoea
- Systemic Lupus Erythematosus
- Testicular Cancer
- Thalassaemia
- Thyroid Diseases
- Travellers' Diseases
- Tuberculosis
- Urinary Tract Infection (UTI)
- Vasculitis
- Vitamin B12 and Folate Deficiency
- Vitamin K Deficiency
- West Nile Virus
- Wilson Disease
- Wound and Skin Infections
Index of Conditions Not Listed? Not Listed? -
Health Screenings